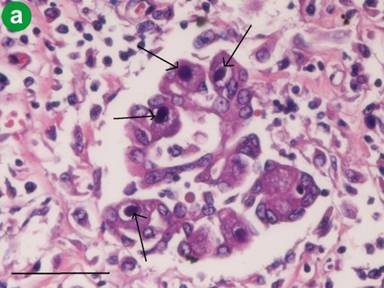

CASE REPORT
JOP. J Pancreas (Online) 2011 Mar 9; 12(2):158-161.
Cytomegalovirus-Associated Severe Fatal Necrotizing Pancreatitis in a Patient with Interstitial Pneumonitis Treated with Steroids. An Autopsy Case
Tadashi Terada
Department of Pathology, Shizuoka City Shimizu Hospital. Shizuoka, Japan
ABSTRACT
Context An autopsy case of cytomegalovirus (CMV) associated with fatal severe pancreatitis is reported. Case report A 76-year-old man presented with high fever and was admitted to our hospital for evaluation. Imaging modalities, including chest X-ray, CT and MRI, revealed interstitial pneumonia. Blood laboratory tests showed positive anti-nuclear antigen (x80), but collagen diseases were not identified. The patient was treated with steroids (prednisolone 30 mg/day). Two months later, the patient developed acute abdominal pain. Serum laboratory tests revealed an elevated amylase level (1,296 IU/L), and CT demonstrated acute pancreatitis. The patient died of multiple organ failure from the acute pancreatitis three days after the onset of the acute pancreatitis. An autopsy revealed severe necrotizing acute pancreatitis. Numerous large inclusions of CMV were found in the acinar and ductal cells of the pancreas. Numerous CMV inclusions were also seen in the degenerated and necrotic pancreatic acinar cells. CMV-infected cells were immunohistochemically positive for CMV antigen, CMV early antigen and CMV late antigen, indicating active replication and regression of CMV. Conclusion The findings strongly suggest that severe CMV infection can occur after steroid administration, and that CMV infection can be the cause of severe fatal acute necrotizing pancreatitis.
INTRODUCTION
Acute pancreatitis occurs in patients with gallstones or in alcoholics. It may be associated with other conditions, including hyperlipidemia, pancreaticobiliary maljunction and drug therapy. Acute pancreatitis also occurs in infections of microorganisms including viruses, bacteria, fungi and parasites [1]. It may also be idiopathic. A severe form of acute pancreatitis may lead to death from multiple organ failure.
Cytomegalovirus (CMV) is a common DNA virus. CMV usually infects immunocompromised patients, such as those with acquired immunodeficiency syndrome (AIDS). However, it can cause infection in people without immunosuppression.
CMV-associated acute pancreatitis is well recognized. It usually occurs in immunocompromised patients including those with AIDS [2], autoimmune diseases [3], organ transplantation [4, 5, 6, 7] and steroid administration. It can also occur in immunocompetent people [8, 9, 10].
The author herein reports a case of fatal severe acute pancreatitis associated with CMV in a patient undergoing steroid administration for interstitial pneumonia. This combination has not yet been reported in the literature.
CASE REPORT
A 76-year-old man presented with high fever and was admitted to our hospital for evaluation. He did not have a history of alcohol consumption. Imaging modalities, including chest X-ray, CT and MR, revealed interstitial pneumonia. Blood laboratory tests showed positive anti-nuclear antigen (x80), but apparent autoimmune diseases were not identified. The patient was treated with steroids (prednisolone 30 mg/day). Two months later, the patient developed acute abdominal pain. Serum laboratory tests revealed an elevated amylase level (1,296 IU/L; reference range: 33-120 IU/L), and CT demonstrated acute pancreatitis. The patient died of multiple organ failure from acute pancreatitis, three days after the onset of the abdominal pain.
An autopsy revealed severe necrotizing acute pancreatitis (Figure 1). The lungs showed interstitial pneumonia. An aortic aneurysm was present. Histologically, the pancreas showed broad necrosis and the infiltration of neutrophils and lymphocytes (Figure 2). Severe fat necrosis was also recognized. Numerous large inclusions of CMV were found in the acinar and ductal cells of the pancreas (Figure 3). Degenerated and necrotic acinar cells also contained numerous CMV inclusions (Figure 4). The islets of Langerhans were free of CMV inclusions.

|
Figure 1. Gross features of the pancreas. The pancreas shows severe necrotizing pancreatitis. |

|
Figure 2. Histology of the acute necrotizing pancreatitis. Broad necrosis and acinar degeneration are seen together with neutrophilic and lymphocytic infiltrations (Bar=200 µm; H&E, x40). |


|
Figure 3. Cytomegalic inclusions. a. The acinar cells and ductal cells contain numerous cytomegalic inclusion bodies (Bar=100µm; H&E, x200). b. The cells with cytomegalic inclusions are positive for immunoreactive cytomegalovirus (Bar=100µm; immunostaining, x200). |

|
Figure 4. Cytomegalovirus in degenerated and necrotic cells. a. Numerous cytomegalic inclusions are recognized in the degenerated acinar cells (Bar=100µm; H&E, x200). b. The degenerated acinar cells contain numerous immunoreactive cytomegalovirus inclusions (Bar=100µm; immunostaining, x200). c. The necrotic acinar cells are positive for cytomegalic inclusions (Bar=100µm; H&E, x200). |
An immunohistochemical study for CMV-related antigens was carried out with the use of DAKO EnVision® (Dako Co., Glostrup, Denmark) method, as previously described [11, 12]. The antibodies were as follows: anti-CMV (CMV pp65, 2 and 6), anti-CMV early antigen (QB1/42), and anti-CMV late antigen (QB1/01) (all antibodies from Novocastra, New Castle upon Type, United Kingdom). The CMV antigen, CMV early antigen and CMV late antigen were immunohistochemically positive in the CMV-infected epithelial cells, indicating active replication and regression of the CMV.
The lungs showed interstitial pneumonia, and a very small number of CMV inclusions were recognized in the alveolar pneumocytes (Figure 5).

|
Figure 5. The lungs show intestinal pneumonitis. A very small number of cytomegalovirus inclusions are seen (Bar=100µm; HE, x200). |
Other pathologic findings were pulmonary edema, mild cardiac hypertrophy, liver congestion, kidney congestion, prostatic hyperplasia and atherosclerosis. No gallstones were noted. The cause of death was multiple organ failure from the acute pancreatitis.
DISCUSSION
No cases of the association between CMV-associated acute pancreatitis and interstitial pneumonitis have been reported in the literature, to the best of the author’s knowledge. There are few case reports of CMV and interstitial pneumonia in immunocompetent people in the literature [13, 14]. In contrast, there are some case reports of CMV and interstitial pneumonia in immunocompromised people [15, 16]. CMV, causing interstitial pneumonia, is usually seen in immunosuppressed individuals, for the most part after transplant. As is well known, steroids can reduce immune responses. In the present case, steroids were used to treat the interstitial pneumonia.
Therefore, there are two hypotheses on the CMV infection in the present case. The first hypothesis is that the interstitial pneumonia of the present case was caused by CMV. After the administration of steroids, the CMV spread to the pancreas which caused severe fatal pancreatitis. The second hypothesis is that the interstitial pneumonia was idiopathic. After the steroid administration for this lung disease, CMV infected the pancreas thus leading to the severe acute pancreatitis. In the present case, CMV inclusions were numerous in the pancreas, and only scattered in the lungs. From these findings, the author favors the second hypothesis. The rarity of CMV inclusions in the lungs favors the second hypothesis. However, it is unclear whether CMV infection in the present case is opportunistic infection in an immunocompromised person or an ordinary infection in an immunocompetent person.
The cause of the present acute pancreatitis is only speculative. In the present case, the patient did not have gallstones and was not an alcoholic. Other causes of acute pancreatitis were absent. Therefore, the author believes that the acute necrotizing pancreatitis in the present case was caused by CMV. The presence of CMV inclusions in degenerated and necrotic acinar cells was in favor of this. In addition, positive CMV early and late antigens, markers of active viral replication and regression, are in favor of the etiological role of CMV in the acute pancreatitis in the present study. Previous case reports [2, 3, 4, 5, 6, 7, 8] also have suggested the etiological role of CMV in CMV-associated pancreatitis. In the present case, it is very likely that the CMV infection occurred due to steroid-induced immunosuppression.
The author hypothesizes the following scenario in this patient. The patient had idiopathic interstitial pneumonitis and received steroids. The steroids led to a subclinical immunosuppressed state. This caused severe CMV infection in the pancreas. The severe infection of CMV in the pancreas gave rise to fatal necrotizing pancreatitis due to the cytotoxic effects of the numerous CMV inclusions. The presence of CMV in degenerated and necrotic cells and the immunoreactivity for CMV early and late antigens strongly support this hypothesis.
In any case, the present findings suggest that CMV infection can occur after steroid administration, and that the CMV infection can be the cause of severe fatal acute necrotizing pancreatitis. In the present case, it is very likely that the CMV infection occurred due to steroid-induced immunosuppression.
Received December 12th, 2010 - Accepted January 11th, 2011
Key words Cytomegalovirus; Pancreatitis, Acute Necrotizing; Steroids
Conflicts of interest The author declares that he does not have any conflict of interest
Correspondence
Tadashi
Terada
Department of Pathology
Shizuoka City Shimizu Hospital
Miyakami 1231 Shimizu-Ku
Shizuoka 424-8636
Japan
Phone: +81-54.336.1111
Fax: +81-54.336.1315
E-mail: piyo0111jp@yahoo.co.jp
References
1. Iwasaki T, Tashiro A, Satodate R, Sata T, Kurata T. Acute pancreatitis with cytomegalovirus infection. Acta Pathol Jpn 1987; 37:1661-8. [PMID 2829502]
2. Bigio EH, Haque AK. Disseminated cytomegalovirus infection presenting with acalculous cholecystitis and acute pancreatitis. Arch Pathol Lab Med 1989; 113:1287-9. [PMID 2554845]
3. Kaşifoğlu T, Korkmaz C, Ozkan R. Cytomegalovirus-induced interstitial pneumonia in a patient with dermatomyositis. Clin Rheumatol 2006; 25:731-3. [PMID 16267608]
4. Tiple A, Kamar N, Esposito L, Mengelle C, Combelles S, Otal P, et al. Unusual presentation of cytomegalovirus infection in patients after organ transplant. Exp Clin Transplant 2009; 7:45-9. [PMID 19364312]
5. Wilcox CM, Forsmark CE, Grendell JH, Darragh TM, Cello JP. Cytomegalovirus-associated acute pancreatic disease in patients with acquired immunodeficiency syndrome: report of two patients. Gastroenterology 1990; 99:263-7. [PMID 2160899]
6. Tomonari A, Takahashi S, Takasugi K, Ooi J, Tsukada N, Konuma T, et al. Pancreatic hyperamylasemia and hyperlipasemia in association with cytomegalovirus infection following unrelated cord blood transplantation for acute myelogenous leukemia. Int J Hematol 2006; 84:438-44. [PMID 17189226]
7. Yasumoto N, Hara M, Kitamoto Y, Nakayama M, Sato T. Cytomegalovirus infection associated with acute pancreatitis, rhabdomyolysis and renal failure. Int Med 1992; 31:426-30. [PMID 1319248]
8. Shimada A, Koga T, Shimada M, Kitajima T, Mitsui T, Sata M, Aizawa H. Cytomegalovirus pneumonitis presenting small nodular opacities. Intern Med 2004; 43:1198-120. [PMID 15645659]
9. Oku T, Maeda M, Waga E, Wada Y, Nagamachi Y, Fujita M, et al. Cytomegalovirus cholangitis and pancreatitis in an immunocompetent patient. J Gastroenterol 2005; 40:987-92. [PMID 16261436]
10. Ikura Y, Matsuo T, Ogami M, Yamazaki S, Okamura M, Yoshikawa J, Ueda M. Cytomegalovirus associated pancreatitis in a patient with systemic lupus erythematosus. J Rheumatol 2000; 27:2715-7. [PMID 11093460]
11. Parenti DM, Steinberg W, Kang P. Infectious causes of acute pancreatitis. Pancreas 1996; 13:356-71. [PMID 8899796]
12. Terada T, Kawaguchi M, Furukawa K, Sekido Y, Osamura Y. Minute mixed ductal-endocrine carcinoma of the pancreas with predominant intraductal growth. Pathol Int 2002; 52:740-6. [PMID 12685552]
13. Andrade ZR, Garippo AL, Saldiva PH, Capelozzi VL. Immunohistochemical and in situ detection of cytomegalovirus in lung autopsies of children immunocompromised by secondary interstitial pneumonia. Pathol Res Pract 2004; 200:25-32. [PMID 15157047]
14. Riddell SR. Pathogenesis of cytomegalovirus pneumonia in immunocompromised hosts. Semin Respir Infect 1995; 10:199-208. [PMID 8668847]
15. Terada T, Kawaguchi M. Primary clear cell adenocarcinoma of the peritoneum. Tohoku J Exp Med 2005; 206:271-5. [PMID 15942157]
16. Margreiter R, Schmid T, Dunser M, Tauscher T, Hengster P, Konigsrainer A. Cytomegalovirus (CMV) -pancreatitis: a rare complication after pancreas transplantation. Transplant Proc 1991; 23:1619-22. [PMID 1846480]